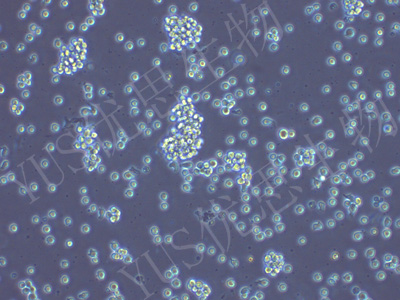

产品中心
产品中心
-

CBRH7919 大鼠肝癌细胞(种属鉴定)
货号:YLR001规格: 1*10^6 -

RBL-2H3 大鼠嗜碱性白血病细胞(种属鉴定)
货号:YLR002规格: 1*10^6 -

OLN-93 大鼠少突胶质前体细胞(种属鉴定)
货号:YLR004规格: 1*10^6 -
GH3 大鼠垂体瘤细胞(种属鉴定)
货号:YLR005规格: 1*10^6 -

INS-1 大鼠胰岛细胞瘤细胞(种属鉴定)
货号:YLR006规格: 1*10^6 -

Walker/LLC-WRC 256 大鼠腹水癌细胞(种属鉴定)
货号:YLR007规格: 1*10^6 -

RSC96 大鼠雪旺细胞(种属鉴定)
货号:YLR008规格: 1*10^6 -

UMR-106 大鼠骨肉瘤细胞(种属鉴定)
货号:YLR009规格: 1*10^6 -

H9C2 大鼠心肌细胞(种属鉴定)
货号:YLR010规格: 1*10^6 -

CFSC-8B 大鼠肝星形细胞(种属鉴定)
货号:YLR011规格: 1*10^6 -

H4-II-E-C3 大鼠肝癌细胞(种属鉴定)
货号:YLR012规格: 1*10^6 -

C6 大鼠脑胶质瘤细胞(种属鉴定)
货号:YLR013规格: 1*10^6
在线咨询
Online consultation

关注微信公众号


